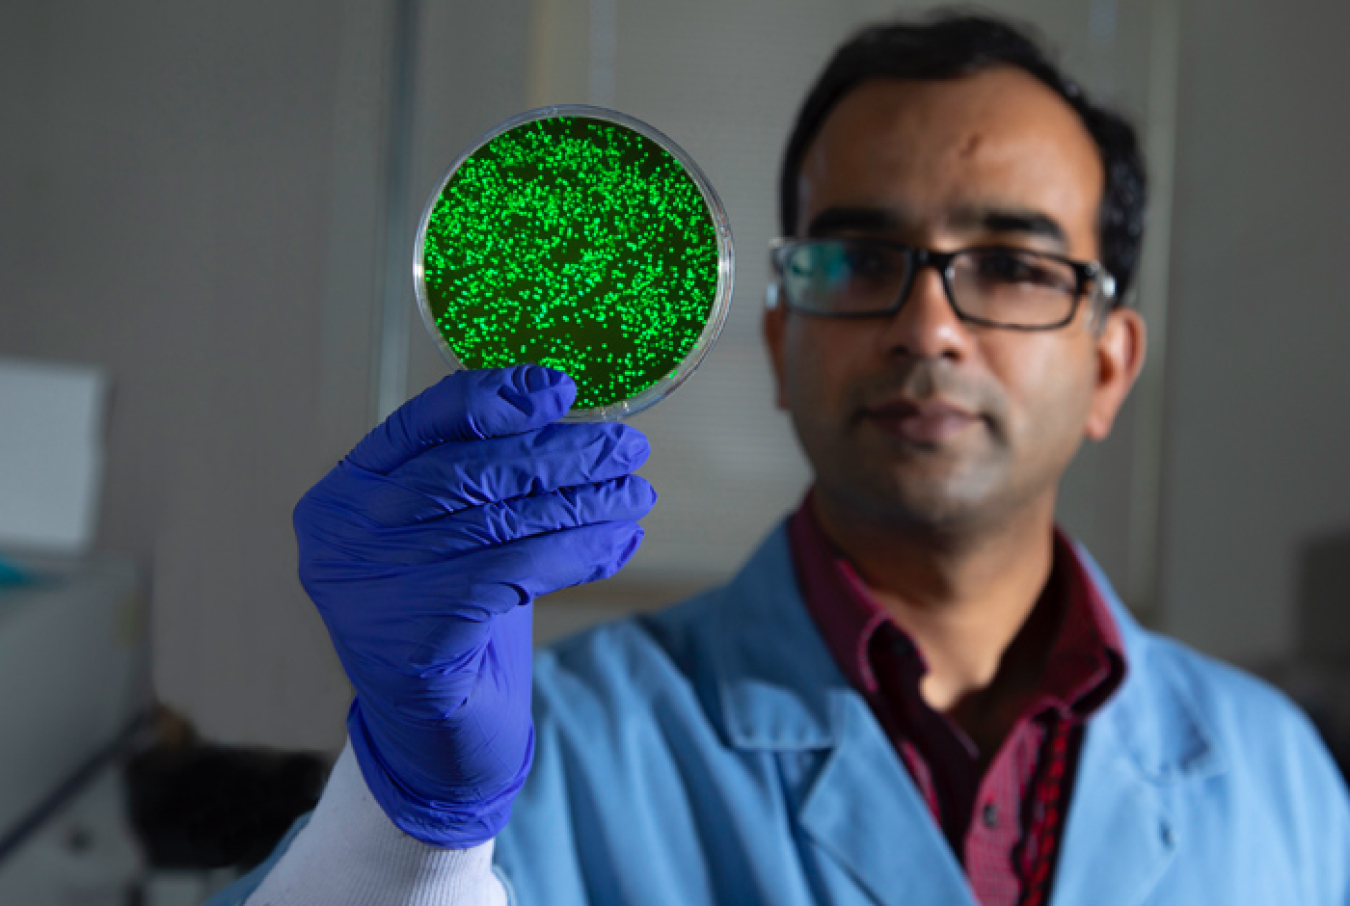

R&D Magazine has named 13 NNSA projects as winners in the annual R&D 100 Awards.
National Nuclear Security Administration
November 6, 2020
Awards often referred to as the ‘Oscars of Innovation’
R&D Magazine has named 13 NNSA projects led by Lawrence Livermore National Laboratory, Los Alamos National Laboratory, the Nevada National Security Site and Sandia National Laboratories as winners in the annual R&D 100 Awards, which honor the 100 most innovative technologies and services of the past year.
The awards, which are often referred to as the “Oscars of Innovation,” were announced in three separate virtual events Sept. 29 and 30 and Oct. 1, 2020.

An independent panel of judges selected the award winners based on the technical significance, uniqueness, and usefulness of projects and technologies from across industry, government, and academia.
Listed below are the winning NNSA labs and site and their corresponding technologies. A complete list of winners can be found at R&D World.
Lawrence Livermore National Laboratory
Versatile Cold Spray deposits a broad range of brittle and glassy materials, including functional materials such as thermoelectric devices and magnets, onto any substrate and in doing so, opens the door to creating thermoelectric generators and other functional components such as permanent magnets and insulators on industrial parts with complex shapes.
Los Alamos National Laboratory
Amanzi-ATS is open-source software that includes the most complete suite of surface/subsurface physical processes to model complex environmental systems across multiple scales.
Cluster Integrity, Exception Resolution and Reclustering Algorithm (CIERRA) is a software tool that analyzes massive amounts of satellite-collected lightning observations to provide the most comprehensive and accurate understanding of lightning data.
Legion Programming System is a data-centric, open-source, high-performance computer software tool that boosts application performance and speed of computing by automating task scheduling and data movement.
Multi-Burn Solid Rocket provides multiple independent thrusts from a single solid rocket to enable small satellites to maneuver, avoid debris, and de-orbit.
OrganiCam is the first camera for noncontact, nondestructive biodetection in remote environments and space.
QUIC-Fire software is the first laptop-capable, fast-running 3D fire-atmosphere feedback model for wildland fire management.
Smart Microbial Cell Technology is an ultra-high-throughput screening platform to engineer custom biocatalysts that enhance the rate of chemical reactions critical in pharmaceuticals, renewable energy, and environmental cleanup.

Spectroscopic Detection of Nerve Agents (SEDONA) is the only portable screener to accurately detect the chemical nerve agents in unopened bottles, providing results in seconds.
Nevada National Security Site
X-ray Polarizing Beam Splitter (XRPBS) has the ability to separate an X-ray beam in two in order to measure each polarized beam simultaneously, which will be used for diagnostics within the Nuclear Security Enterprise.
Sandia National Laboratories
Binary Solvent Diffusion for Fabrication of Large Nanoparticle Supercrystals was created using nanotechnology and chemistry to self-assemble gold nanoparticles into millimeter-sized supercrystals that are sensitive to chemical traces. The supercrystals obtained through this process also proved to have superior qualities in optoelectronics, photovoltaics, and surface catalysis.
High-density Evaluator of Commercial-off-the-shelf Applications for Trust and Efficacy (HECATE) is a software supply chain and assurance platform that reduces the risks for users of commercial and open-source software.
Tracktable applies advanced machine-learning techniques to large trajectory data sets, searching for shapes and patterns in space and time by providing a mathematical framework that describes particular arrangements of data.